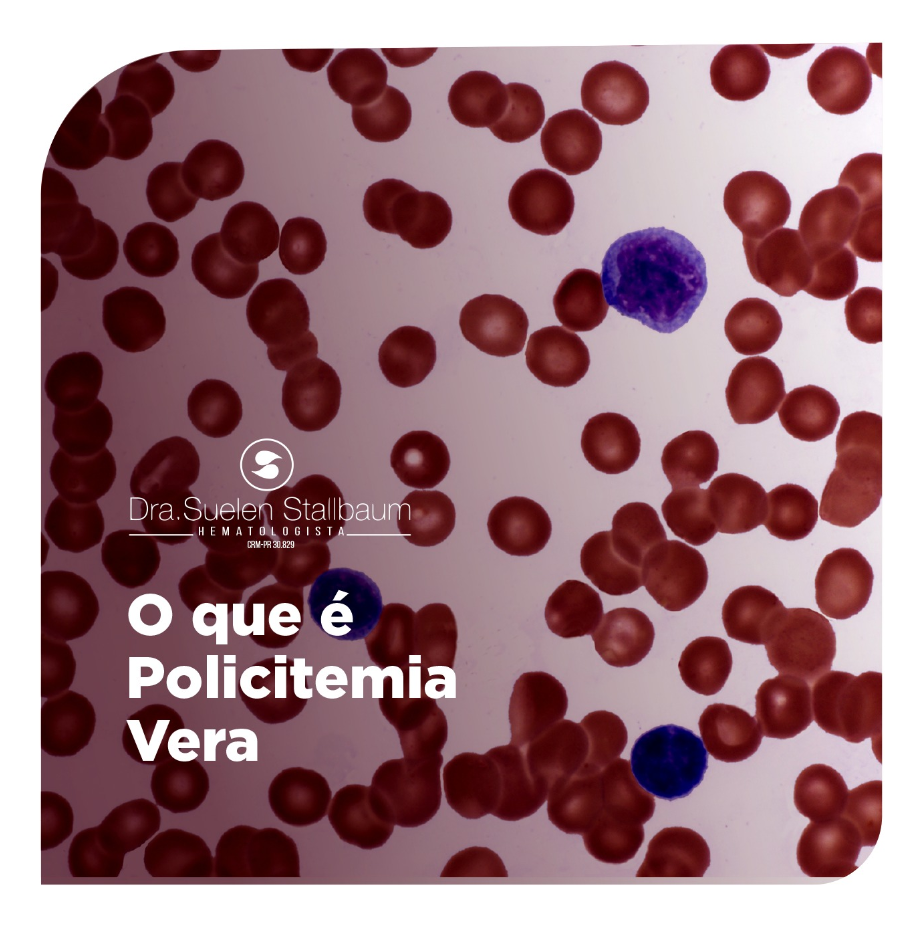
tratamento para policitemia

Você sabia que seu sangue pode ficar ‘grosso’ a ponto de aumentar o risco de um AVC ou infarto? A policitemia é exatamente isso: um excesso anormal de glóbulos vermelhos que transforma o sangue em uma espécie de ‘lama’ circulante. E o pior é que muita gente descobre essa condição só depois de uma emergência.
Antes de continuar, um aviso importante: este conteúdo é informativo e não substitui uma consulta médica. Se você suspeita de policitemia, procure um hematologista para diagnóstico e tratamento adequados.
O que é policitemia? Entenda a diferença entre primária e secundária
A policitemia se divide em dois tipos principais: a Policitemia Vera (PV) e a policitemia secundária. A PV é uma doença rara da medula óssea, geralmente ligada a uma mutação no gene JAK2, que faz o corpo produzir hemácias sem controle. Já a secundária é uma reação a condições como tabagismo, DPOC, apneia do sono ou viver em grandes altitudes.
O grande perigo está no sangue espesso: com mais glóbulos vermelhos, a viscosidade aumenta e o coração precisa trabalhar mais. Isso eleva o risco de trombose, derrame e infarto. Estima-se que a PV atinja cerca de 2 a 3 pessoas a cada 100 mil, mas muitos casos de policitemia secundária passam despercebidos.
No hemograma, os valores de alerta são hemoglobina acima de 16,5 g/dL em homens e 16 g/dL em mulheres, além do hematócrito elevado. Se você tem sintomas como dor de cabeça persistente, coceira após banho quente, fadiga ou vermelhidão na pele, fique atento: pode ser policitemia.
Policitemia: O Sangue que Engrossa e os Riscos que Você Precisa Conhecer

Vamos combinar, quando falamos de saúde, a última coisa que queremos é que nosso sangue se torne um problema. Mas a verdade é que a policitemia, essa condição onde o número de glóbulos vermelhos sobe demais, é exatamente isso: um risco real para o coração e o cérebro. Esse excesso faz o sangue ficar mais viscoso, como um rio que transborda e perde a fluidez, abrindo portas para tromboses e eventos graves.
Pode confessar, a ideia de um sangue ‘espeso’ soa preocupante, e é mesmo. Essa condição não é brincadeira e exige atenção médica séria. Entender o que é policitemia e seus gatilhos é o primeiro passo para se proteger e garantir que sua saúde siga em frente, sem percalços.
| Condição | Descrição | Causas Principais | Sintomas Comuns | Diagnóstico |
| Policitemia Vera (PV) | Doença mieloproliferativa crônica com produção descontrolada de células sanguíneas pela medula óssea. Frequentemente associada à mutação JAK2. | Mutações genéticas (ex: JAK2). | Dores de cabeça, tontura, zumbido, prurido intenso, vermelhidão, fadiga, falta de ar, esplenomegalia. | Hemograma (hemoglobina/hematócrito elevados), testes genéticos. |
| Policitemia Secundária | Aumento de hemácias como resposta a outros fatores. | Hipóxia crônica (altitude, tabagismo, DPOC), apneia do sono, uso de testosterona, desidratação severa. | Variam conforme a causa base; podem incluir os mesmos da PV. | Hemograma, avaliação da causa subjacente. |
O que é policitemia vera
A policitemia vera, ou PV, é uma doença rara do sangue. Ela faz com que a medula óssea produza glóbulos vermelhos em excesso, sem que o corpo precise deles. Essa produção descontrolada, muitas vezes ligada a uma mutação no gene JAK2, é o cerne do problema. O resultado direto é um sangue mais grosso, com maior risco de formar coágulos.
Essa condição crônica exige acompanhamento médico contínuo. O objetivo principal é controlar a quantidade de células sanguíneas e prevenir as complicações sérias que podem surgir, como o temido risco de trombose.
Sintomas da policitemia vera

Olha só, os sintomas da policitemia vera podem ser sutis no início, mas não devem ser ignorados. Dores de cabeça persistentes, tonturas e um zumbido incômodo nos ouvidos são sinais de alerta. A pele pode ficar avermelhada, e uma coceira intensa, especialmente após um banho quente, é um sintoma clássico que muitos pacientes relatam.
A fadiga excessiva e a falta de ar, mesmo em repouso, são indicativos claros de que o sangue não está circulando como deveria. O aumento do baço (esplenomegalia) também pode causar desconforto abdominal.
É crucial ficar atento a esses sinais. Ignorá-los pode atrasar o diagnóstico e o início do tratamento, aumentando os riscos associados ao sangue espesso.
Causas da policitemia
A causa primária da policitemia vera é, na maioria das vezes, uma mutação genética, como a do gene JAK2. Essa alteração faz com que a medula óssea trabalhe em ritmo acelerado, fabricando células sanguíneas em excesso. É como se o ‘controle de qualidade’ da medula falhasse, liberando uma quantidade anormal de glóbulos vermelhos.
Já a policitemia secundária surge como uma resposta do corpo a outras condições. Falta de oxigênio (hipóxia) crônica, seja por viver em grandes altitudes, por doenças pulmonares como a DPOC, ou até mesmo pelo tabagismo, pode levar o corpo a produzir mais hemácias para tentar compensar. Apneia do sono e o uso de testosterona também entram nessa lista de gatilhos.
Diagnóstico de policitemia
O diagnóstico começa com um bom papo com o médico e um exame físico detalhado. Mas a confirmação, meu amigo, vem mesmo com o hemograma. Nele, vamos observar níveis de hemoglobina e hematócrito acima do normal. Em 2026, os valores de referência para homens geralmente ultrapassam 16.5 g/dL e para mulheres, 16 g/dL, mas isso pode variar.
Para a policitemia vera, testes genéticos para identificar mutações como a JAK2 são essenciais. A avaliação da causa subjacente é fundamental no caso da policitemia secundária, garantindo que o tratamento seja direcionado corretamente.
Tratamento para policitemia
O tratamento da policitemia foca em duas frentes: controlar a produção de células e prevenir complicações. A sangria terapêutica, ou flebotomia, é uma das armas mais usadas. Consiste em remover o excesso de sangue para diminuir a viscosidade e o risco de trombose. É um procedimento simples, mas que exige regularidade.
Medicamentos como a hidroxiureia podem ser prescritos para reduzir a produção de células pela medula óssea. A aspirina em baixa dose é frequentemente recomendada para ajudar a prevenir a formação de coágulos. Em casos mais raros e graves, o transplante de medula óssea pode ser considerado como uma opção curativa, mas é um procedimento complexo e de alto risco.
Policitemia secundária vs primária
A grande diferença entre a policitemia secundária e a primária (como a Vera) está na causa. A primária é uma doença da própria medula óssea, uma falha interna. Já a secundária é uma adaptação do corpo a um problema externo, como a falta de oxigênio.
Entender essa distinção é vital para o tratamento. Na secundária, o foco é tratar a condição que está causando o aumento das hemácias. Na Vera, o manejo é direto na medula e na viscosidade do sangue. O diagnóstico correto, portanto, é o pulo do gato.
Risco de trombose na policitemia
Aqui está o detalhe que mais assusta: o risco de trombose. Com o sangue mais espesso devido ao excesso de glóbulos vermelhos, a circulação fica mais difícil. Isso aumenta drasticamente a chance de coágulos se formarem nas veias e artérias.
Esses trombos podem levar a eventos gravíssimos como infarto do miocárdio e acidente vascular cerebral (AVC). A prevenção, através do controle da viscosidade sanguínea e, quando indicado, do uso de medicamentos anticoagulantes ou antiplaquetários, é a chave para reduzir esse perigo iminente.
Policitemia e coceira
A coceira intensa, conhecida como prurido aquagênico, é um sintoma bastante característico da policitemia vera. Ela costuma piorar após o contato com água, especialmente em banhos quentes. A sensação pode ser extremamente incômoda e persistente, afetando a qualidade de vida do paciente.
Embora a causa exata não seja totalmente compreendida, acredita-se que esteja relacionada à liberação de substâncias pelas células sanguíneas anormais. O controle da doença e, em alguns casos, o uso de anti-histamínicos ou outras medicações específicas podem ajudar a aliviar esse sintoma angustiante.
O Veredito de 2026: Controle e Prevenção são o Caminho
Em 2026, a policitemia continua sendo um desafio médico, mas o cenário é de maior controle e otimismo. Os avanços no diagnóstico, especialmente genético, permitem identificar a condição mais cedo. As terapias, focadas em reduzir a viscosidade e a produção celular, mostram-se cada vez mais eficazes na prevenção de tromboses e outras complicações graves.
A mensagem que fica é clara: não subestime os sinais do seu corpo. Dores de cabeça frequentes, fadiga inexplicável ou coceiras que não passam podem ser mais do que um incômodo. Busque orientação médica especializada. Com o acompanhamento correto e o tratamento adequado, é totalmente possível viver bem e com qualidade, mesmo diante da policitemia.
Este conteúdo é informativo, consulte um especialista.
Diretrizes essenciais para o manejo da policitemia
- Monitore regularmente o hematócrito e a hemoglobina com exames de sangue a cada três meses. Ajustes na terapia são feitos com base nesses valores.
- Mantenha-se bem hidratado para evitar a concentração adicional do sangue. Evite diuréticos e bebidas alcoólicas em excesso.
- Evite o tabagismo e a exposição a altitudes elevadas, que podem agravar a hipóxia e estimular a produção de hemácias.
- Realize atividade física moderada de forma regular, mas evite exercícios extenuantes que aumentem o risco de trombose.
- Consulte um hematologista antes de usar suplementos de ferro ou testosterona, pois podem interferir no tratamento.
Perguntas frequentes sobre policitemia
Policitemia tem cura?
A Policitemia Vera não tem cura definitiva, mas o tratamento controla a doença e previne complicações. A policitemia secundária geralmente é reversível ao tratar a causa subjacente.
Quais os primeiros sinais de policitemia?
Os sintomas iniciais incluem dor de cabeça persistente, tontura, coceira intensa após banho quente e vermelhidão na pele. Muitos pacientes são assintomáticos e descobrem a condição em exames de rotina.
Policitemia pode virar câncer?
A Policitemia Vera é considerada uma neoplasia mieloproliferativa crônica, com potencial de evolução para mielofibrose ou leucemia aguda. O acompanhamento hematológico reduz esse risco.
A policitemia é uma condição que exige monitoramento contínuo e adesão ao tratamento para evitar eventos trombóticos graves. A abordagem multidisciplinar, com hematologista e clínico geral, é a chave para o sucesso terapêutico.
Se você apresentar sintomas sugestivos ou alterações no hemograma, busque avaliação médica especializada sem demora. O diagnóstico precoce e o manejo adequado transformam o prognóstico.
O futuro do tratamento inclui terapias alvo-moleculares e maior individualização do cuidado. A medicina de precisão promete melhorar ainda mais a qualidade de vida dos pacientes.

